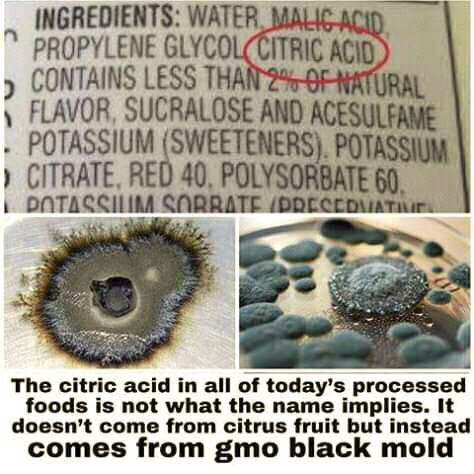

STAY HEALTHY
Teaching the World Basic's that they should know already...
Or is this a Business Decision not to teach. #NWO
Anarchy - Well Isn't it - Secret Warfare...!






The Pineal Gland: The Secret The Illuminati Has Kept From Humanity
EAT NATURAL FOODS
The Pineal Gland: The Secret The Illuminati Has Kept From Humanity
https://www.youtube.com/watch?v=4dewpLF3Fzwhttps://www.youtube.com/watch?v=4dewpLF3Fzw
Ancient cultures knew about the Pineal Gland and its importance thousands of years ago.
Today, most people know very little about the Pineal Gland and why ancient cultures believed it was so important.
The Illuminati is determined to keep us in the dark about the powerful portal that lies deep within the central part of our brains.
There is only one major conspiracy at play in the world today. The Illuminati – a cabal of interconnected global elites – and their plan to control humanity
and usher in a totalitarian New World Order. Employing a cunning ruse straight out of the devil’s playbook, the Illuminati employ their propaganda
organs to convince the world they do not exist, while they continue tightening the noose around humanity’s neck. Thousands of years ago, cultures like the ancient Egyptians and Greeks knew that the pineal gland was of great importance to humans. But the elite cabal have suppressed this knowledge, determined to convince humanity that they are nothing more than soulless consuming machines, slaves to the disappearing dollars, and of weak flesh. But the existence of the Pineal Gland, aka the third eye, terrifies the Illuminati. Modern science tells us that it is a small cone-shaped part in our brain that is responsible for producing serotonin derivative melatonin which directly deals with our hormones which in turn modulate sleep, wake patterns, and our seasonal functions. But it is also much, much more. Today, little information is shared about the Pineal Gland which according to many researchers can help humanity achieve its full potential, and defeat our tyrannical overlords. It is considered by many as a portal that connects the physical and spiritual world in humans. When activated, the Pineal Gland offers a sensation of euphoria, and oneness that fills the mind, providing a sense of knowledge and enlightenment. Interestingly, remote viewing has been researched by the government. In fact, Stanford scientists observed a “man travel outside his body and into space”. He was able to accurately view and describe a ring around Jupiter, a ring that scientists had no idea even existed until the Pioneer 10 spacecraft flew past Jupiter years later. All of this was said to be achieved via the Pineal Gland. However, not only were Stanford scientists and the US government working on projects related to the Pineal Gland, the former Soviet Union was very interested in the portal buried in our brain, and numerous shadow organizations have also been quietly studying the power of the Pineal Gland for decades. But the information, results and potential benefits related to the Pineal Gland have largely been locked away from humanity by the elites. Interestingly, the ancients knew about the power of the pineal gland, and through a number of ancient methods and practices –which have been lost for centuries— ancient man was able to control thoughts and actions of other people in the physical world. Why are we not able to use the full potential of the Pineal Gland today? An interesting question that deserves a rather simple answer. It is believed that the full potential of the pineal gland is locked due to the amount of SODIUM FLOURIDE people ingest each day. The Pineal Gland is believed to absorb most of the sodium fluoride that enters our body. It is believed that this causes the Pineal Gland to work with less ‘juice’ creating an unbalance between hormonal processes in our body. Interestingly further study related to the Pineal Gland takes us to Rick Strassman, M. D. who firmly believes DMT is highly connected to the pineal gland.
FOOD MEDICINE AND HISTORY - THE LOSTED WAY.
Lesson No. 1: Don't Take Anything for Granted!
"Those who cannot remember the past are condemned to repeat it."
This milky substance inside this plant doesn't contain any opiates, but it's acting directly on the central nervous system (CNS) to lessen the feeling of pain. Many people have used it as a replacement for addictive prescription pain medicine.
Wild Lettuce is un-scheduled by the FDA, meaning it is legal to forage, to grow, and own without prescription or license..
just like the Native Americans used it to heal their pain.
Sᴏᴍᴇᴏɴᴇ ᴛᴇʟʟ ᴍᴇ ᴡʜʏ..
Wʜʏ ᴅᴏɴ’ᴛ ᴅᴏᴄᴛᴏʀs ᴛᴇʟʟ ʏᴏᴜ ᴛᴏ ᴛᴀᴋᴇ ᴍᴀɢɴᴇsɪᴜᴍ ɪɴsᴛᴇᴀᴅ ᴏғ sᴛᴏᴏʟ sᴏғᴛᴇɴᴇʀs? (ᴡʜɪᴄʜ ᴅᴇʜʏᴅʀᴀᴛᴇs ᴛʜᴇ ʙᴏᴡᴇʟ)
Wʜʏ ᴅᴏɴ’ᴛ ᴅᴏᴄᴛᴏʀs ᴛᴇʟʟ ʏᴏᴜ ᴛᴏ ᴄʜᴀɴɢᴇ ʏᴏᴜʀ ᴅɪᴇᴛ ᴡʜᴇɴ ʏᴏᴜ ʜᴀᴠᴇ ʜᴇᴀʀᴛ ʙᴜʀɴ ᴀɴᴅ ɪɴᴅɪɢᴇsᴛɪᴏɴ ɪɴsᴛᴇᴀᴅ ᴏғ ɢɪᴠɪɴɢ ʏᴏᴜ Pʀɪʟᴏsᴇᴄ? (ᴛʜɪs ᴄᴀᴜsᴇs ᴍᴏʀᴇ ʜᴇᴀʀᴛʙᴜʀɴ, ᴄᴏʟᴏɴ ᴄᴀɴᴄᴇʀ & ᴏsᴛᴇᴏᴘᴏʀᴏsɪs ᴀɴᴅ ʟᴇᴀᴠᴇs ғᴏᴏᴅ ғᴇʀᴍᴇɴᴛɪɴɢ ɪɴ ʏᴏᴜʀ ʙᴏᴅʏ)
Wʜʏ ᴅᴏɴ’ᴛ ᴅᴏᴄᴛᴏʀs ᴛᴇʟʟ ʏᴏᴜ ᴛʜᴀᴛ ʜᴇʀʙs ᴀɴᴅ ᴄᴇʀᴛᴀɪɴ ғᴏᴏᴅs ᴄᴀɴ ᴀʟsᴏ ʜᴇᴀʟ?
Wʜʏ ᴅᴏɴ’ᴛ ᴅᴏᴄᴛᴏʀs ᴛᴇʟʟ ʏᴏᴜ ᴛᴏ ʟᴏᴡᴇʀ ᴛᴏxɪᴄ ᴄʜᴇᴍɪᴄᴀʟs ɪɴ ʏᴏᴜʀ ʜᴏᴍᴇ ᴀɴᴅ ᴡʜᴇɴ ʏᴏᴜ ʜᴀᴠᴇ ᴄᴏɴsᴛᴀɴᴛ ʜᴇᴀᴅᴀᴄʜᴇs ᴀɴᴅ ᴀʟʟᴇʀɢɪᴇs? (ᴛʜᴇsᴇ ғʀᴀɢʀᴀɴᴄᴇ & ᴄʜᴇᴍɪᴄᴀʟs ᴄᴀᴜsᴇ ᴛᴏxɪᴄ ʙᴜɪʟᴅᴜᴘ ɪɴ ᴏᴜʀ ᴄᴇʟʟs ᴀɴᴅ ᴄᴀᴜsᴇs ᴍᴏʀᴇ ᴀʟʟᴇʀɢɪᴇs ᴀɴᴅ ʜᴇᴀᴅᴀᴄʜᴇs)
Wʜʏ ᴀʀᴇɴ’ᴛ ʏᴏᴜ ɪɴғᴏʀᴍᴇᴅ ʙʏ ʏᴏᴜʀ ᴅᴏᴄᴛᴏʀ ᴛʜᴀᴛ ɪғ ʏᴏᴜ ᴇᴀᴛ ᴀ ɢʀᴀᴘᴇғʀᴜɪᴛ ᴇᴠᴇʀʏᴅᴀʏ, ɪᴛ ᴡɪʟʟ ʟᴏᴡᴇʀ ʏᴏᴜʀ ʙʟᴏᴏᴅ ᴘʀᴇssᴜʀᴇ ɴᴀᴛᴜʀᴀʟʟʏ ᴀɴᴅ ʏᴏᴜ ᴅᴏɴ’ᴛ ɴᴇᴇᴅ ? (ᴛʜɪs ɪs ᴡʜʏ ᴀ ᴘᴇʀsᴏɴ ᴄᴀɴ’ᴛ ᴇᴀᴛ ɪᴛ ᴡʜɪʟᴇ ᴏɴ ʙʟᴏᴏᴅ ᴘʀᴇssᴜʀᴇ ᴍᴇᴅs)
Wʜʏ ᴅᴏᴇsɴ’ᴛ ʏᴏᴜʀ ᴅᴏᴄᴛᴏʀ ᴛᴇʟʟ ʏᴏᴜ ᴛᴏ ᴛᴀᴋᴇ ᴀᴄᴛɪᴠᴀᴛᴇᴅ ᴄʜᴀʀᴄᴏᴀʟ ғᴏʀ ʜᴇᴀᴅᴀᴄʜᴇs, ʙʟᴏᴀᴛɪɴɢ/ɢᴀs, sᴋɪɴ ɪssᴜᴇs, ᴄᴏʟᴅs, ғᴏᴏᴅ ᴘᴏɪsᴏɴɪɴɢ? (ᴀᴄᴛɪᴠᴀᴛᴇᴅ ᴄʜᴀʀᴄᴏᴀʟ ʙᴏɴᴅs ᴡᴀsᴛᴇ/ᴛᴏxɪɴs ғᴏʀ ᴛʜᴇ ʀᴇᴍᴏᴠᴀʟ ғʀᴏᴍ ᴛʜᴇ ʙᴏᴅʏ)
Wʜʏ ᴅᴏɴ’ᴛ ᴅᴏᴄᴛᴏʀs ᴛᴇʟʟ ʏᴏᴜ ᴀʙᴏᴜᴛ ʜᴇʀʙs ᴀɴᴅ ʜᴇʀʙᴀʟ ᴛᴇᴀs ᴛᴏ sᴜᴘᴘᴏʀᴛ ɪᴍᴍᴜɴᴇ ᴀɴᴅ ᴅɪɢᴇsᴛɪᴠᴇ ғᴜɴᴄᴛɪᴏɴs? (ᴅɪғғᴇʀᴇɴᴛ ʜᴇʀʙs ʜᴇʟᴘ ᴅɪғғᴇʀᴇɴᴛ ᴏʀɢᴀɴs ᴅᴏ ᴛʜᴇɪʀ ᴊᴏʙs ᴛᴏ ᴋᴇᴇᴘ ᴛʜᴇ ʙᴏᴅʏ ʜᴇᴀʟᴛʜʏ)
Wʜʏ ɪsɴ’ᴛ ʏᴏᴜʀ ᴅᴏᴄᴛᴏʀ sᴜɢɢᴇsᴛɪɴɢ ᴛʜᴀᴛ ʏᴏᴜ ᴛᴀᴋᴇ ᴀ ᴘʀᴏʙɪᴏᴛɪᴄ ᴅᴀɪʟʏ? (ᴛʜɪs ʙᴏᴏsᴛ ɪᴍᴍᴜɴᴇ ғᴜɴᴄᴛɪᴏɴ, ʜᴇʟᴘs ᴄʟᴇᴀɴ ᴀɴᴅ ʙᴀʟᴀɴᴄᴇ ᴛʜᴇ ʙᴏᴡᴇʟ, ʜᴇʟᴘs ʀᴇɢᴜʟᴀᴛᴇ ᴀʙsᴏʀᴘᴛɪᴏɴ ᴀɴᴅ ᴇʟɪᴍɪɴᴀᴛɪᴏɴ, ᴋᴇᴇᴘs ᴄᴏʟᴅs ᴀɴᴅ ᴀʟʟᴇʀɢɪᴇs ᴀᴛ ʙᴀʏ)
Wʜʏ ᴅᴏɴ’ᴛ ᴅᴏᴄᴛᴏʀs ᴄʀᴇᴀᴛᴇ ᴅɪᴇᴛ/ʟɪғᴇsᴛʏʟᴇ ᴘʟᴀɴs ғᴏʀ ᴘᴀᴛɪᴇɴᴛs ɪɴsᴛᴇᴀᴅ ᴏғ ᴏғғᴇʀɪɴɢ ᴀ ᴘɪʟʟs? (ᴅɪᴇᴛ & ʟɪғᴇsᴛʏʟᴇ ᴄʜᴏɪᴄᴇs ᴀʀᴇ 90+% ᴄᴀᴜsᴇ ᴏғ ᴀʟʟ ɪʟʟɴᴇss)
Wʜʏ ᴅᴏɴ’ᴛ ᴅᴏᴄᴛᴏʀs ᴛᴇʟʟ ʏᴏᴜ ᴛᴏ ᴛᴀᴋᴇ sᴜᴘᴘʟᴇᴍᴇɴᴛs ᴛᴏ ʙᴏᴏsᴛ ʏᴏᴜʀ ʜᴇᴀʟᴛʜ ᴘʀɪᴏʀ ᴛᴏ ʙᴇᴄᴏᴍɪɴɢ sɪᴄᴋ ᴀɴᴅ ᴛʜᴇɴ ᴛʜᴇʏ ʀᴇᴄᴏᴍᴍᴇɴᴅ ᴘɪʟʟs
(sᴜᴘᴘʟᴇᴍᴇɴᴛs/ʜᴇʀʙs/ᴛɪɴᴄᴛᴜʀᴇs ᴄᴀɴ ᴘʀᴇᴠᴇɴᴛ ɪʟʟɴᴇss ʙʏ ʙᴏᴏsᴛɪɴɢ ɪᴍᴍᴜɴᴇ ғᴜɴᴄᴛɪᴏɴ ᴀɴᴅ sᴜᴘᴘᴏʀᴛɪɴɢ ᴏʀɢᴀɴs ᴡɪᴛʜ ᴛʜᴇɪʀ ɴᴀᴛᴜʀᴀʟ ғᴜɴᴄᴛɪᴏɴs)?
Wʜʏ ᴅᴏɴ’ᴛ ᴅᴏᴄᴛᴏʀs ᴛᴇᴀᴄʜ ʏᴏᴜ ᴛʜᴀᴛ ʏᴏᴜʀ ᴇᴍᴏᴛɪᴏɴs sᴛᴏʀᴇᴅ ɪɴ ʏᴏᴜʀ ᴘʜʏsɪᴄᴀʟ ʙᴏᴅʏ ᴄᴀɴ ᴄᴀᴜsᴇ ʏᴏᴜ ᴍᴇɴᴛᴀʟ ᴀɴɢᴜɪsʜ, ɪɴsᴛᴇᴀᴅ ᴛʜᴇʏ sᴀʏ ʏᴏᴜ ɴᴇᴇᴅ ᴍᴇᴅɪᴄᴀᴛɪᴏɴ (ᴇᴍᴏᴛɪᴏɴs ᴄᴀɴ ᴘʟᴀʏ ᴀ ᴠᴇʀʏ sɪɢɴɪғɪᴄᴀɴᴛ ʀᴏʟʟ ɪɴ ᴏᴜʀ ᴛᴏᴛᴀʟ ʜᴇᴀʟᴛʜ, ᴡɪᴛʜᴏᴜᴛ ᴛᴏᴏʟs ᴛᴏ ʜᴇʟᴘ ɴᴀᴠɪɢᴀᴛᴇ ᴏᴜʀ ᴇᴍᴏᴛɪᴏɴs ᴡᴇ ᴄᴀɴ ᴇᴀsɪʟʏ ʙᴇᴄᴏᴍᴇ ᴘʜʏsɪᴄᴀʟʟʏ ɪʟʟ)?
Wʜʏ ᴅᴏɴ’ᴛ ᴅᴏᴄᴛᴏʀs ᴛᴀᴋᴇ ᴀ ʀᴇᴀʟ ʀᴏʟᴇ ɪɴ ʜᴇʟᴘɪɴɢ ᴘᴇᴏᴘʟᴇ ᴛᴏ ʟɪᴠᴇ ʙᴇᴛᴛᴇʀ ʟɪᴠᴇs?
Wʜʏ ᴅᴏ ᴛʜᴇʏ sᴇᴛ ᴜᴘ ᴛʜᴇsᴇ ᴘʀᴏᴛᴏᴄᴏʟs ᴏғ ᴘɪʟʟs ᴛʜᴀᴛ ᴍᴏsᴛ ᴏғ ᴛʜᴇᴍ ᴡᴏᴜʟᴅɴ’ᴛ ᴇᴠᴇɴ ᴛᴀᴋᴇ?
Wʜʏ ᴀʀᴇɴ’ᴛ ᴡᴇ ʙᴇɪɴɢ ʜᴇʟᴘᴇᴅ ᴛᴏ ʙᴇ ʜᴇᴀʟᴛʜʏ ʙᴇғᴏʀᴇ ᴡᴇ ɢᴇᴛ sɪᴄᴋ?
Tʜɪs ɴᴇᴇᴅs ᴛᴏ ᴄʜᴀɴɢᴇ!
Hᴇᴀʟɪɴɢ ɪs REAL, ᴀɴᴅ ᴘᴏssɪʙʟᴇ!
Wᴇ ᴊᴜsᴛ ᴀʀᴇɴ’ᴛ ɢᴇᴛᴛɪɴɢ ᴛʜᴇ ʀɪɢʜᴛ ɪɴғᴏʀᴍᴀᴛɪᴏɴ ғʀᴏᴍ ᴛʜᴇ ᴘᴇᴏᴘʟᴇ ᴡᴇ ᴡᴇʀᴇ ᴛᴀᴜɢʜᴛ ᴛᴏ ᴛʀᴜsᴛ!
Aɴᴏɴʏᴍᴏᴜs.
IF YOU ARE BREATHING ON LIFE SUPPORT AND CIRULATION IS WORKING - YOU ARE STILL LIVING. See link:-

Since 1963,
"BRAIN-DEATH"
(ON LIFE-SUPPORT)
has always been
PREMEDITATED
MURDER
OF THE
HEALTHY...
THIS INCLUDES
ALL
HARVESTING
OF VITAL ORGANS!

Create Your Own Website With Webador